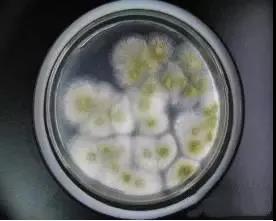

- 新聞資訊
多角度講解微生物在乳品中的污染及控制
發(fā)布時(shí)間:2020-09-30 信息來(lái)源:鄭州耕宇科技有限公司 瀏覽次數(shù):次
隨著人們生活質(zhì)量的逐漸提高,乳制品已經(jīng)成為人們?nèi)粘I钪械谋匦杵?,逐漸步入廣大人民群眾的日常生活當(dāng)中。尤其是近些年來(lái)乳品加工技術(shù)得到了長(zhǎng)足的發(fā)展,但在微生物污染與控制上,仍需要進(jìn)一步的完善和改進(jìn)。
01
乳品中微生物的種類(lèi)!

常見(jiàn)的微生物包括:細(xì)菌、酵母菌、霉菌等三大類(lèi)。
1.1 細(xì)菌
乳品中常見(jiàn)的細(xì)菌重要有沙門(mén)氏菌、大腸桿菌、蠟狀芽孢桿菌、李斯特菌、乳桿菌、鏈球菌等。
1.2 酵母菌
乳品種常見(jiàn)的酵母菌有漢氏酵母、脆壁酵母、假絲酵母、原酵母屬等。

1.3 霉菌
乳品中主要霉菌有毛霉、根霉、曲霉等,大多霉菌屬有害菌。
02
乳品微生物的入侵途徑
微生物具有極強(qiáng)的適應(yīng)能力,尤其是生鮮牛乳中微生物會(huì)按照外部條件變化而產(chǎn)生相應(yīng)的變化,其數(shù)量會(huì)受到一定的影響,乳品的加工和銷(xiāo)售環(huán)節(jié)是除了貯藏和運(yùn)輸?shù)然经h(huán)節(jié)外,最易受微生物污染的環(huán)節(jié)。因此也可以說(shuō)微生物污染是無(wú)處不在的,也并不夸張,微生物入侵乳品的方法也是各種各樣的。
03
乳品微生物的防治措施
3.1原料乳中的微生物控制
3.1.1 控制牛體、牛舍、周邊環(huán)境的衛(wèi)生,建立和實(shí)施擠奶機(jī)械、輸奶管線及儲(chǔ)奶設(shè)施的清洗消毒管理制度和衛(wèi)生驗(yàn)證程序。保證外界環(huán)境對(duì)牛奶不會(huì)造成嚴(yán)重污染。
3.1.2 落實(shí)奶牛每年的兩疫檢疫及奶牛的日常體檢,確保奶牛的健康,避免牛乳中含有微生物毒素(主要來(lái)源是牛患有化膿性乳房炎,使得細(xì)菌在牛乳中繁殖產(chǎn)生霉素或者是牛食用了霉變的飼料使得乳中含有黃曲霉毒素)。奶牛飼料不得腐爛,細(xì)菌總數(shù)不得過(guò)高,不含或少含致病菌,不含毒性化學(xué)物質(zhì),不含放射性物質(zhì)等。
3.2原料乳的儲(chǔ)存和運(yùn)輸過(guò)程中的微生物控制
3.2.1 牛乳擠取后立即過(guò)濾到經(jīng)消毒的容器中,并迅速冷卻至4℃以下,減少牛奶后期微生物增殖及污染。
3.2.2 牛奶在儲(chǔ)存期間可適當(dāng)攪拌,杜絕激烈攪拌,減少牛奶中空氣含量。
3.2.3 運(yùn)輸中要盡量減少顛簸、牛乳劇烈晃動(dòng)而致使牛乳溫度上升,牛乳最高溫度不能超過(guò)8℃。
3.2.4 牛乳擠出后應(yīng)在十二小時(shí)內(nèi)運(yùn)送到工廠加工。
3.2.5 運(yùn)輸途中,盡量避免外源性污染。
3.3加工過(guò)程中的微生物控制
3.3.1 減少生鮮牛乳的存放時(shí)間,及時(shí)進(jìn)行凈乳、巴氏殺菌,耐熱芽孢總數(shù)應(yīng)控制在100 CFU/每毫升以?xún)?nèi)。
3.3.2 合理設(shè)定UHT滅菌機(jī)組的滅菌參數(shù),既要保證滅菌效果又要保證營(yíng)養(yǎng)成分損失最小.
3.3.3 盡量減少添加劑中的芽孢菌總數(shù),對(duì)添加劑中芽孢含量較高的產(chǎn)品要進(jìn)行預(yù)殺菌,如生產(chǎn)巧克力牛奶時(shí),要對(duì)巧克力粉(塊)進(jìn)行預(yù)殺菌。
3.3.4 經(jīng)常檢查用于包裝或管線消毒的化學(xué)消毒劑濃度是否足夠(如雙氧水,濃度要求在30%--50%),消毒劑對(duì)包材內(nèi)表面必須涂抹均勻且侵潤(rùn)良好,包裝材料在存放過(guò)程中應(yīng)密封貯存以免微生物污染,確保CIP清洗效果良好。
3.3.5 監(jiān)控和保持罐裝過(guò)程中的無(wú)菌環(huán)境不受破壞。
3.3.6 包裝過(guò)程中,按設(shè)備操作要求抽檢包裝的封口質(zhì)量,避免因封合質(zhì)量不合格,導(dǎo)致外源性微生物后期污染。
3.4成品乳制品在運(yùn)輸和銷(xiāo)售過(guò)程中的衛(wèi)生要求
乳制品一般采用多層復(fù)合材料包裝,該材料具有隔光隔氧及防水的功能,但機(jī)械強(qiáng)度較弱,因此對(duì)此產(chǎn)品而言,儲(chǔ)運(yùn)過(guò)程中要防止碰撞擠壓,減少對(duì)包裝材料的機(jī)械損傷。
綜上所述,食品安全大于天,各個(gè)環(huán)節(jié)都要注意,這樣才能保證外面的乳制品安全放心。


